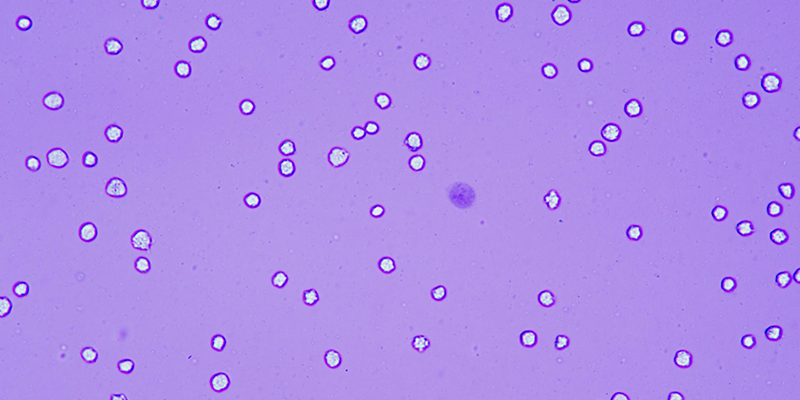

在細胞實驗中,活率計數(shù)是評估細胞狀態(tài)的核心指標,臺盼藍染色與 AOPI 熒光染色作為主流方法,常讓研究者在選擇時陷入權(quán)衡。事實上,二者并無絕對優(yōu)劣,僅存在場景適配差異 ——博大博聚-全自動細胞計數(shù)儀,正是能精準支撐兩種需求的全能工具。
臺盼藍染色作為沿用數(shù)十年的經(jīng)典方法,憑借操作便捷、成本可控的優(yōu)勢,至今仍是基礎實驗室的首選。其原理是利用活細胞完整的細胞膜對染料的排斥作用:活細胞不被染色,死細胞因細胞膜破損被染成藍色,整個染色-計數(shù)流程可在幾分鐘內(nèi)完成。對于常規(guī)細胞傳代、教學實驗等對效率要求高的場景,這種“即染即測”的特性尤為實用。
但臺盼藍染色的局限性也需正視:
① 時效性嚴格:染色后需在10分鐘內(nèi)完成檢測。這是因為活細胞對臺盼藍的排斥是暫時的——長時間暴露于染料中,臺盼藍的細胞毒性會逐漸破壞活細胞膜完整性,導致原本存活的細胞被染色,最終使活率檢測值偏低。在高通量實驗中,若批量樣本處理間隔過長,極易出現(xiàn)前后數(shù)據(jù)偏差。
②-復雜樣本適應性弱:對于直徑較小的細胞(如外周血單個核細胞,PBMC)或含大量雜質(zhì)的樣本,臺盼藍的明場檢測模式易受干擾。由于雜質(zhì)與細胞在形態(tài)、顏色上區(qū)分度低,顯微鏡下難以精準識別,可能導致漏計(誤將小細胞當作雜質(zhì))或錯計(誤將雜質(zhì)當作細胞)。

此時,AOPI 熒光染色的優(yōu)勢便凸顯出來。AOPI熒光染色通過兩種核酸染料的協(xié)同作用實現(xiàn)精準區(qū)分:吖啶橙(AO)可穿透所有細胞膜,與活細胞、死細胞的核酸結(jié)合,在488nm 激發(fā)光下發(fā)出綠色熒光;碘化丙啶(PI)同樣能與核酸結(jié)合,但僅能通過破損的細胞膜進入死細胞,在535nm激發(fā)光下發(fā)出紅色熒光——最終呈現(xiàn) “活細胞綠、死細胞紅” 的清晰信號。

博大博聚-全自動細胞計數(shù)儀搭載明場+雙色熒光通道:明場通道適配臺盼藍染色,雙色熒光通道:488nm 激發(fā) / 525nm 發(fā)射通道捕捉 AO 綠色信號,535nm 激發(fā) / 610nm 發(fā)射通道識別 PI 紅色信號,即使是早期凋亡(細胞膜輕微破損)的細胞也能被精準判定。更重要的是,熒光信號的特異性讓 AOPI 對復雜樣本的耐受性遠超臺盼藍:處理含大量細胞碎片、血清顆粒的樣本時,雜質(zhì)不會產(chǎn)生熒光信號,不干擾計數(shù);
當然,AOPI 熒光染色也有需注意的短板:
① 成本較高:AOPI熒光染料成本顯著高于臺盼藍染料;
② 操作要求更嚴:熒光染料易受強光淬滅,需避光操作(染色后、檢測前需避免直射光),否則可能因信號衰減導致計數(shù)偏差。
因此,在基礎實驗、學生訓練等對成本敏感且樣本簡單的場景,臺盼藍仍是性價比之選;而在生物制藥(如 CAR-T 細胞制備)、復雜樣本分析(如 PBMC 活性檢測)等對精度要求嚴苛的場景,AOPI 顯然更具優(yōu)勢。
博大博聚-全自動細胞計數(shù)儀通過模塊化設計實現(xiàn) “一鍵切換”:臺盼藍染色模式支持高通量快速計數(shù),AOPI熒光染色模式搭載 AI 智能算法(可自動識別細胞與雜質(zhì)、拆分聚團細胞),兼顧效率與精度。無論你是高校實驗室的教學研究者,還是生物制藥企業(yè)的GMP級質(zhì)控人員,都能找到適配方案。

選擇哪種染色?答案藏在你的實驗需求里。而博大博聚-全自動細胞計數(shù)儀,始終是那個懂你所需的可靠伙伴,讓每一次活率計數(shù)都精準高效。